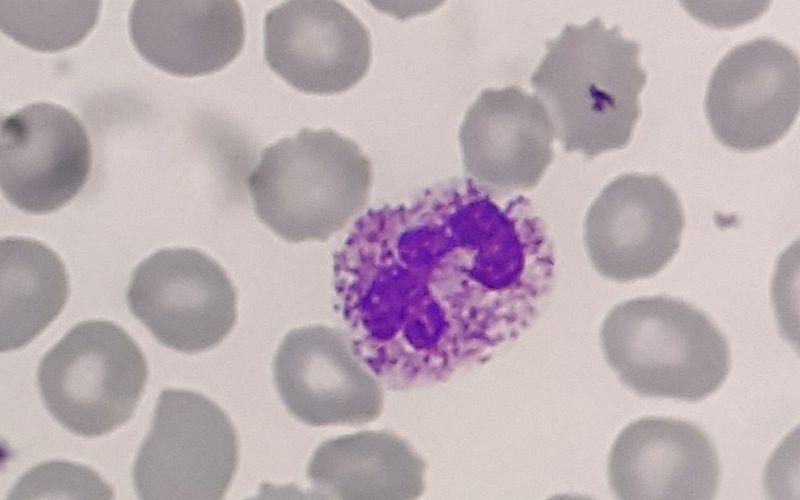

Desviación leucocitaria. En hematología una desviación de la serie blanca, desviación en los leucocitos, desviación leucocitaria o desviación de la fórmula leucocitaria es un cambio en el recuento diferencial o fórmula leucocitaria, con cambios en las proporciones entre las diferentes etapas de desarrollo de los granulocitos.. Un conteo sanguíneo alto de neutrófilos es una señal de que algo en su cuerpo ha desencadenado una respuesta inmunitaria. La neurofilia puede ser causada por una infección, inflamación crónica o trastornos como la leucemia mieloide crónica. Infecciones. Enfermedades infecciosas agudas, como la varicela, así como infecciones bacterianas.

Células importantes en hematología DESVIACION A LA IZQUIERDA

Células De Neutrófilos Segmentadas En Frotis De Sangre Humana Imagen de archivo Imagen de

De neutrófilos y monocitos (izquierda) (a la derecha) glóbulos blancos en frotis de sangre

Leucócitos LACES

Repaso rápido sobre los Leucocitos + VIDEO Medicina mnemotecnias

Neutrófilos hipersegmentados Saiba o que é Blog do Portal Educação

Neutrófilos Definición, función y valores en sangre

La maduración de un neutrófilo Hematología, Histología, Microbiología

Inclusiones citoplasmáticas con aspecto de cuerpos de HowellJolly en los neutrófilos de un

Neutrofilos uDocz

Alteracion DE LOS Neutrófilos Hematología Serie Blanca MORFOLOGÍA CARACTERÍSTICAS CLÍNICAS

Neutrófilo Hipersegmentado en 2022 Hematología, Histología, Medicos

Así es el efecto de los neutrófilos desconocido y con nuevas posibilidades terapéuticas

Atlas de trastornos hematológicos

Neutrófilos Definición, función y valores en sangre

Desviación a izquierda y signos inmunofenotípicos de displasia en serie... Download Scientific

leucocitosis con desviacion a la izquierda. YouTube

fichero hematologia Desviación a la derecha

Inclusiones azulverdosas en los neutrófilos de fallo hepático como señal de muerte
Neutrófilos qué son, características, morfología, funciones, desarrollo
La fórmula de leucocitos o formula leucocitaria es la parte de la hematimetría que mide el porcentaje presente de cada tipo de leucocitos en el total de glóbulos blancos. Al ser un porcentaje, si aumenta un grupo de leucocitos, disminuye otro, aunque en ocasiones solo existe un aumento o disminución de un tipo concreto y por ello solo el.. Conceptos clave. |. La neutropenia es una reducción del recuento de neutrófilos sanguíneos. Si es severa, aumentan el riesgo y la gravedad de las infecciones bacterianas y micóticas. Pueden pasar inadvertidos los síntomas focales de infección, pero hay fiebre durante la mayoría de las infecciones graves.